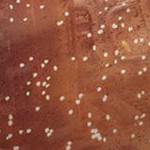
luke skywalker

Sponsored




Star Wars Rebel Alliance Portrait MagSafe Compatible Cell Phone Case for Apple iPhone
$64.99
sizeiphone 16 plus
In Stock
Eligible for registries and wish lists
At a glance
Sponsored
About this item
Highlights
- Premium leatherette over polycarbonate shell
- Passes 4.9ft drop test per MIL-STD-810H
- Wireless Charging and Magsafe Compatible
- Designed and printed in Tualatin, Oregon, USA.
- Officially licensed product.
- Verify phone model before purchase to ensure fit
- Ships in recyclable FSC-certified Glassine bag
Description
This stylish and practical case sports an officially licensed design and is MagSafe compatible. Ideal for fans, enthusiasts, and everyday users who want a slim, protective, and MagSafe compatible case. Premium black leatherette and anodized aluminum buttons ensure a comfortable grip and great tactile response. Precise speaker and port cutouts and integrated magnets optimize compatibility with accessories and wireless charging devices. It is drop-tested to 4.9 feet for a perfect balance between bulk and protection and is designed and decorated by Keyscaper in Tualatin, Oregon, USA.
Model Compatibility: Apple iPhone 16 Plus
Dimensions (Overall): 6.46 inches (H) x .44 inches (W) x 3.2 inches (D)
Weight: .05 pounds
Electronics Condition: New
Electronics Features: Wireless Charging Compatible, Sturdy Construction, Snap-On Case, No-Scratch Lining, Microfiber Lining, MagSafe Compatible, Hard Case
Protective Qualities: Bump-Resistant, Scratch-Resistant, Scuff-Resistant
Package Quantity: 1
Product Name: Star Wars Rebel Alliance Portrait MagSafe Compatible Cell Phone Case
Material: Leatherette
Battery: No Battery Used
Warranty: 1 Year Limited Warranty. To obtain a copy of the manufacturer's or supplier's warranty for this item prior to purchasing the item, please call Target Guest Services at 1-800-591-3869
TCIN: 1001531413
UPC: 198905575836
Origin: made in the USA and imported
The above item details were provided by the Target Plus™ Partner. Target does not represent or warrant that this information is accurate or complete. On occasion, manufacturers may modify their items and update their labels.
We recommend that you do not rely solely on the information presented. If you have a specific question about this item, you may consult the item's label, contact the manufacturer directly or call Target Guest Services at 1-800-591-3869.
If the item details aren’t accurate or complete, we want to know about it.
Shipping details
Estimated ship dimensions: 12 inches length x 8 inches width x 1 inches height
Estimated ship weight: 0.19 pounds
This item cannot be shipped to the following locations: American Samoa (see also separate entry under AS), Guam (see also separate entry under GU), Northern Mariana Islands, Puerto Rico (see also separate entry under PR), United States Minor Outlying Islands, Virgin Islands, U.S., APO/FPO, Alaska, Hawaii
item ships from third party seller: Keyscaper
Return details
This item can be returned to any Target store or Target.com.
This item must be returned within 30 days of the date it was purchased in store, shipped, delivered by a Shipt shopper, or made ready for pickup.
See the return policy for complete information.